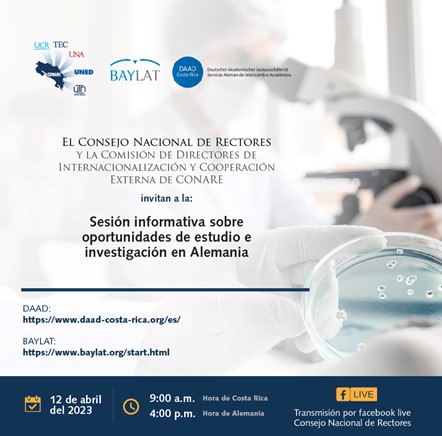

La Dirección de Cooperación tiene el gusto de compartir la siguiente invitación sobre la Sesión Informativa denominada: Oportunidades de estudio e investigación en Alemania. Este evento es organizado por el Consejo Nacional de Rectores y la Comisión de Directores de Internacionalización y Cooperación Externa del CONARE.